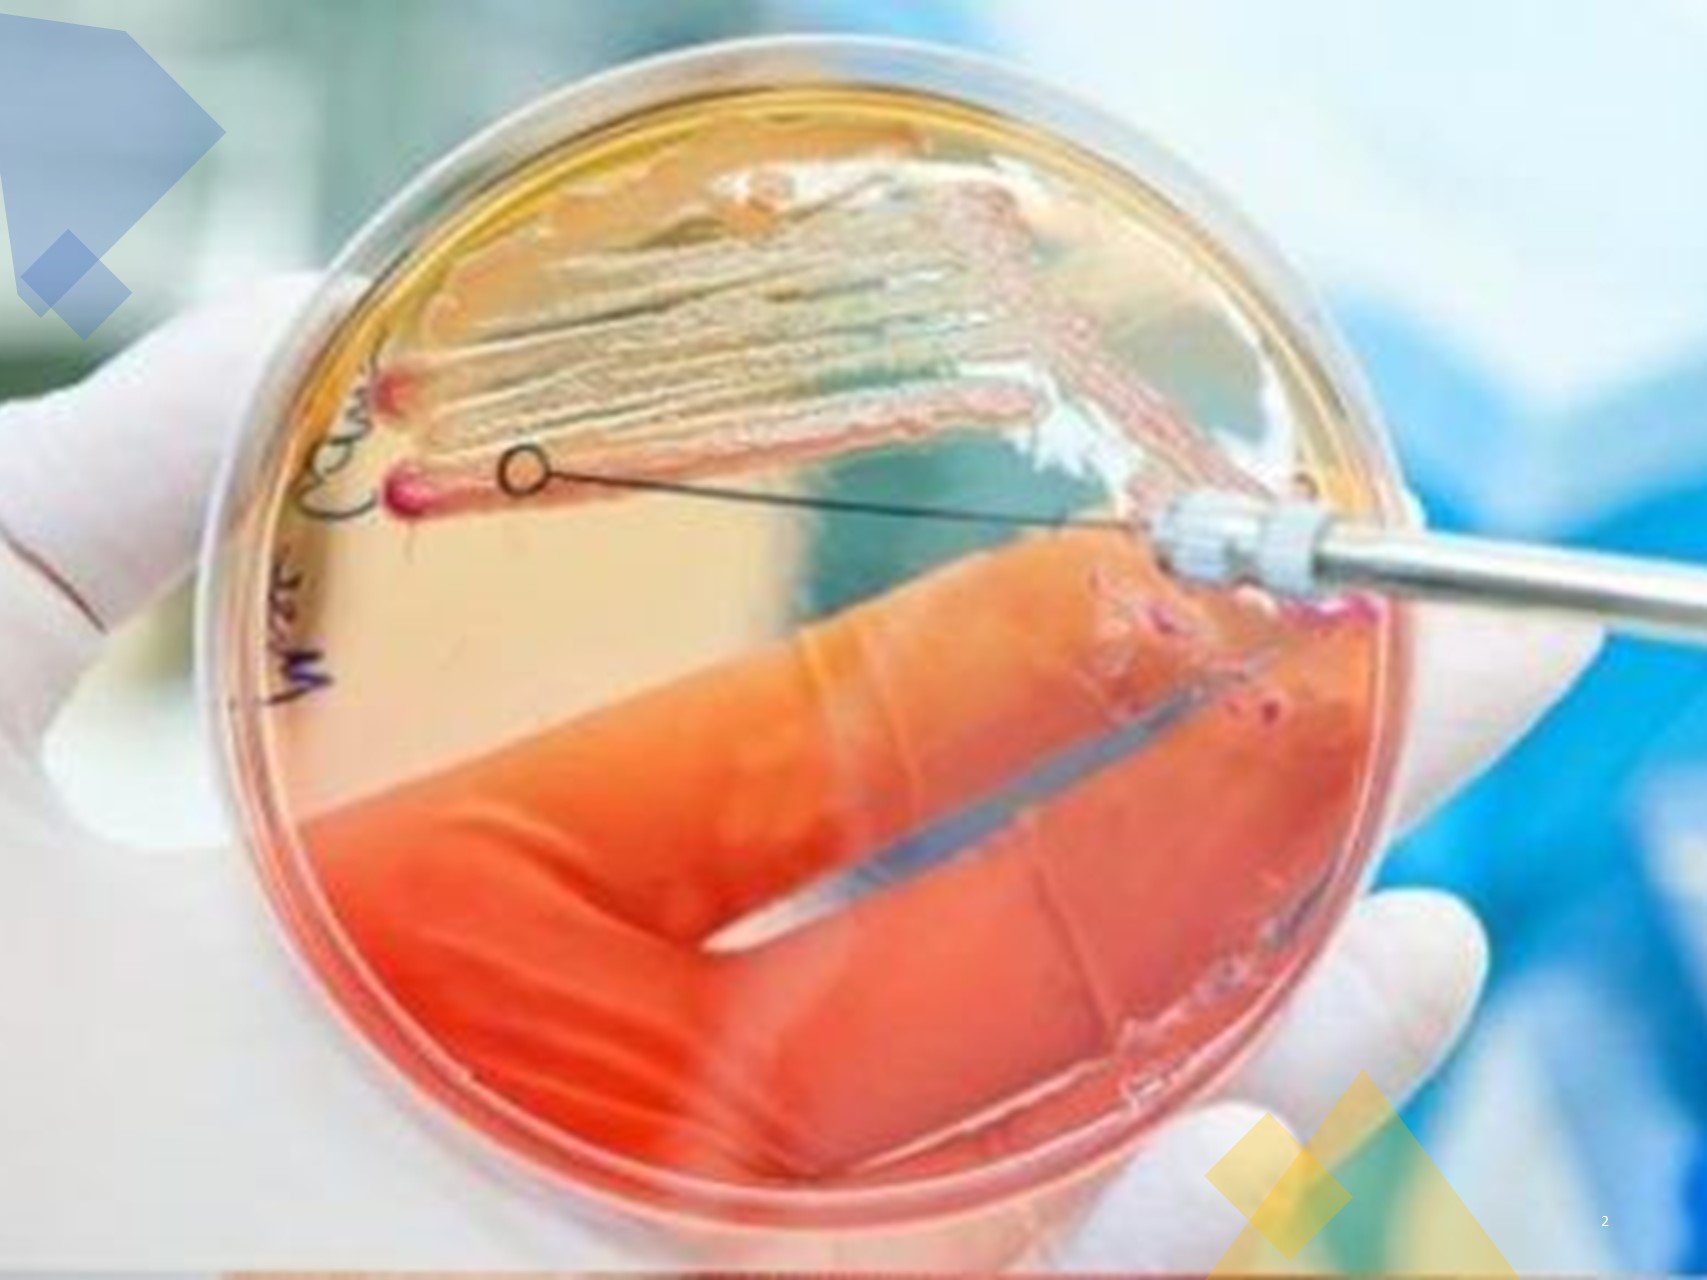

Stope uspjeha in vitro oplodnje (IVF) su daleko od savršenog. [1] Naše znanje o procesu implantacije je nepotpuno. Na primjer, koji čimbenici pomažu implantaciji i koji sprečavaju uspjeh? Kronični endometritis je identificiran kao jedna od patologija povezanih s ponavljanim neuspjehom implantacije. Nedavni sustavni pregled je procijenio utjecaj kroničnog endometritisa na uspjeh IVF-a. [2]
Rezultati meta-analize
U ovoj meta-analizi su uključeni rezultati pet studija (ukupno 796 pacijentica) koje su procijenile povezanost između kroničnog endometritisa i ponavljanih neuspjeha implantacije (dva ili više neuspjelih IVF ciklusa). U svim su studijama su uzete biopsije endometrija u folikularnoj fazi i bojenje hematoksilin-eozinom za stanice plazme ili imunohistokemijski postupak za potvrdu kroničnog endometritisa. Doksiciklin, ciprofloksacin i metronidazol su bili preporučeni za liječenje stanja. Izvršene su usporedbe, sa sljedećim nalazima:
- Nije bilo utjecaja kroničnog endometritisa na klinički ishod kada je liječen kronični endometritis (nije provedena nikakav kontrola liječenja) naprema netretiranom kroničnom endometritisu na temelju rezultata jedne studije.
- Klinički ishodi su se značajno poboljšali nakon izlječenja (provedena je kontrola liječenja) kroničnog endometritisa u usporedbi s trajnim kroničnim endometritisom.
- Klinički ishodi su bili slični nakon izlječenja kroničnog endometritisa u usporedbi sa slučajevima nekroničnih endometritisa. Natalitet živorođenčadi, stopa kliničke trudnoće i stopa implantacije nisu se značajno razlikovale.
Autori istraživanja su zaključili da liječenje kroničnog endometritisa rezultira boljim kliničkim rezultatima nakon IVF-a u usporedbi s perzistirajućom bolesti. Liječenje treba, međutim, potvrditi ponavljanom biopsijom. Ovi nalazi temelje se na podacima dobivenim iz retrospektivnih i prospektivnih opservacijskih studija, ali ne i randomiziranih kontroliranih ispitivanja; stoga, autori pozivaju na buduća klinička istraživanja o ovoj temi.
Uspješna implantacija zahtijeva zdravi, euploidni embrij, receptivni endometrij i odgovarajuću sinhronizaciju. Među svim metodama reproduktivne tehnologije, IVF nudi najveće šanse za postizanje trudnoće. Ipak, stopa uspjeha IVF-a je daleko od savršene. [1] Čak i jedan neuspjeli ciklus može biti stresan, ali ponavljajući implantacijski neuspjeh je frustrirajući i za pacijente i za pružatelje usluga. Dijagnosticiranje i liječenje potencijalno izlječivih stanja kao što je endometritis može pretvoriti neuspjeh u uspjeh.
Kronični endometritis je patološki stanje uzrokovano mikrobiološkim infekcijama. Većina infekcija je uzlazno, ali može se širiti i kroz krvotok ili limfni sustav. Šupljina maternice nije sterilna. Njen mikrobiološki sastav sličan je mikrobiološkim sastavu donjeg genitalnog trakta, ali manje dominiraju lactobacilli (30% vs 99% pronađenih u vagini / cerviksu).
Bakterije (Escherichia coli, Enterococcus, Mycoplasma, Klebsiella, Pseudomonas, Gardnerella itd.) kao i kvasci mogu biti odgovorni za kronični endometritis. Mogu prerasti kada se smanji broj dominantnih laktobacila.
Kronični endometritis može pokrenuti upalni proces koji smeta implantaciji, može inducirati abnormalne histološke promjene endometrija i može rezultirati promjenama u ekspresijskom profilu gena. Proliferacija endometrija se smanjuje, što dovodi do suboptimalne debljine endometrija.
Čini se, na temelju ovog i drugih sustavnih pregleda, da su oralni antibiotici (doksiciklin, klindamicin, ciprofloksacin, metronidazol itd.) učinkoviti u liječenju kroničnog endometritisa. Ponovljena biopsija bi trebala potvrditi liječenje, jer se ishodi trudnoće poboljšavaju samo u izlječenim slučajevima.
Samo biopsija može imati pozitivan učinak na implantaciju ako se izvrši u ciklusu prije prijenosa. [4] Stoga, ako je potrebna biopsija u sklopu obrade, trebala bi biti planirana neposredno prije ciklusa za prijenos da bi se imalo koristi od njenog potencijalnog pozitivnog učinka na implantaciju, čak i ako se histologija pokazala negativnom.
Reference
1. European IVF-monitoring Consortium (EIM); European Society of Human Reproduction and Embryology (ESHRE), Calhaz-Jorge C, De Geyter C, Kupka MS, et al. Assisted reproductive technology in Europe, 2013: results generated from European registers by ESHRE. Hum Reprod. 2017;32:1957-1973.
2. Vitagliano A, Saccardi C, Noventa M, et al. Effects of chronic endometritis therapy on in vitro fertilization outcome in women with repeated implantation failure: a systematic review and meta-analysis. Fertil Steril. 2018;110:103-112.
3. Kitaya K, Takeuchi T, Mizuta S, Matsubayashi H, Ishikawa T. Endometritis: new time, new concepts. Fertil Steril. 2018;110:344-350.
4. Vitagliano A, Di Spiezio Sardo A, Saccone G, et al. Endometrial scratch injury for women with one or more previous failed embryo transfers: a systematic review and meta-analysis of randomized controlled trials. Fertil Steril. 2018;110:687-702.